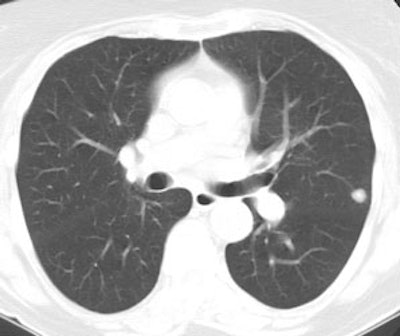
Granuloma Ct

PET Imaging in Bronchogenic Carcinoma:
Click here for a discussion of the use of PET FDG imaging in the staging of bronchogenic carcinoma
General:
The PET agent 2-(fluorine-18) fluo-2-deoxy-D-glucose (18-FDG) has been the most studied for evaluation of bronchogenic carcinoma. 18-FDG competes with glucose for facilitated transport into tumor cells and also competes with glucose for phosphorylation by hexokinase. Unlike glucose, however, the phosphorylated form is not further metabolized, it becomes trapped within the cell with little back diffusion or degradation. Uptake of FDG therefore reflects regional rates of exogenous glucose utilization. The agent is useful for imaging bronchogenic carcinoma because lung tumor cells have an increased cellular uptake of glucose due to an increased number of surface glucose transport proteins (increased Glut-1 glucose transporter expression) and a higher rate of glycolysis in comparison to non-neoplastic cells (ie: lung cancer cells have an increased metabolic rate). FDG uptake is related to the degree of cell differentiation and increased FDG uptake is generally associated with greater degrees of de-differentiation [1]. FDG uptake is also related to the proliferation potential of lung cancer as estimated by the proliferating cell nuclear antigen labeling index [1]
FDG PET imaging can have a significant impact on patient management by heightening suspicion for pulmonary malignancy, identifying unsuspected sites of disease, and by guiding selection of a biopsy site. Similarly, a negative PET scan indicates a low likelihood for malignancy and supports the use of conservative management and follow-up [40]. In a study evaluating the impact of FDG PET exam results in the clinical management of patients with suspected or known thoracic malignancies PET scans influenced treatment in 65% of patients and offered new information in 85% [40].
Solitary Pulmonary Nodule Evaluation:
The differential for a solitary pulmonary nodule (SPN) is quite broad, but a large percentage of these lesions may prove to be malignant (especially if the lesion is larger than 2 cm). In the evaluation of an SPN, only 10-20% of patients with malignancy will have sputum positive for cancer [5]. Additionally, up to 30% of patients with negative transthoracic biopsies are ultimately found to have malignancy [5].
Standard uptake value: FDG
PET imaging can be used to evaluate indeterminate solitary
pulmonary nodules to determine whether the nodule is benign or
malignant. A standardized uptake ratio (SUR) or standard uptake
value (SUV), representing the maximum or mean tumor uptake, is
used to determine if a lesion has increased FDG activity. The SUV
normalizes the amount of FDG accumulation in a region of interest
(ROI) to the total injected dose and the patient's body weight (or
some other measure of body size) [97]. It provides a means of
comparison of FDG uptake between patients [41]. The SUV is
calculated by dividing the mean activity within a selected region
of interest (in mCi/ml) by the injected dose (in mCi/kg).
Modifications of the SUV that may improve the semiquantitative
evaluation of FDG uptake include using body surface area or the
lean body weight instead of the weight of the patient; this is
significant because the accumulation of FDG is higher in muscle
than in fat [44]. Additionally, normalization to body surface area
or lean body mass potentially reduce the effect of weight loss
(which may occur during therapy) on subsequent SUV determinations
[76]. It is also important to remember that SUV values may change
with time after FDG injection; thus, the time of acquisition after
FDG injection must be standardized for the values to be useful
[25,76]. Other factors which can affect the SUV include
partial-volume effects, patient motion (due to lesion blurring),
and the blood glucose level at the time of injection [46,53].
Mis-registration between the PET and CT exams lead to
underestimation of the SUV and false negative results [122].
Respiratory averaged CT for attenuation correction has shown max
SUV differences of more than 50% compared to standard
mid-expiration CT [122].
For SUV measurements to be accurate, the PET scanner should be routinely evaluated for quantitative integrity [76]. Repeat measurements of SUVmean performed a few days apart are highly reproducible [91].
SUV= Mean selected region activity (mCi/ml)/injected dose (mCi)/body weight (kg)
SUVmax= the maximum SUV value within a defined ROI. The SUV max has been shown to suffer from less interobserver variability and provides an excellent representation of tumor glucose metabolism [87].
An SUVmax greater than 2.5 has been shown to be very sensitive and specific for malignant lesions [13].
Visual analysis of the amount of uptake within a lesion has also been shown to be effective in differentiating benign from malignant lesions [13,47,71]. Uptake greater than blood pool activity (i.e.: the liver or mediastinum typically have an SUV of 2.0) is considered indicative of a malignant lesion, while activity equal to or less than mediastinal blood pool suggests a benign lesion [47]. Overall, visual analysis may be more sensitive for nodules smaller than 1.5 cm in size (although, the improved sensitivity comes at a decreased specificity) [47]. In fact, solid pulmonary lesions with low FDG uptake are probably better evaluated based upon visual inspection [71]. Lesions with visually absent uptake have a very low probability for malignancy, while any visually evident tracer uptake (even faintly visible) within the lesion is associated with about a 60% probability for malignancy [71]. Therefore, any lesion that is visually detectable on FDG PET imaging should be considered carefully for the possibility of malignancy [71,77]. Luckily, most malignant pulmonary nodules with SUV values of less than 2.5 are differentiated adenocarinomas [71].
High sensitivities (82-100%), specificities (67-100%), and
accuracy (79-94%) have been reported for the identification of
pulmonary malignancy using FDG PET imaging [25,47,50,52,77]. In a
prospective multicenter study for the evaluation of pulmonary
nodules (larger than 7 mm) felt to be indeterminate for malignancy
based upon their conventional imaging appearance, FDG PET had a
sensitivity of 92% and a specificity of 90% using SUR data [47].
Visual analysis of the images demonstrated a sensitivity of 98%,
but a lower specificity of 69% [47]. A meta-analysis performed in
2008 revealed an overall sensitivity of 95%, a specificity of 82%,
a PPV of 91%, and NPV of 90% [86]. However, if the pretest
likelihood for malignancy is greater than 50%, the post-test
probability for disease will exceed 10% even if the FDG PET scan
is negative and histopathologic evaluation will still be required
[68]. Combined PET/CT imaging has been shown to have improved
sensitivity and specificity for lesion characterization compared
to either CT or PET alone [79]. In a comparison to dynamic
contrast enhanced CT imaging, PET/CT has been shown to have a
higher specificity [77], sensitivity [72], and accuracy [72].
The findings on the FDG PET exam should always be interpreted in
conjunction with clinical risk factors and imaging features of the
nodule [122]. For instance, in a patient with a high pre-test
likelihood (80%) for malignancy, negative findings on the PET scan
only reduce the likelihood of malignancy to 14%; while in a
patient with a low pre-test likelihood (20%), a negative FDG PET
scan reduces the likelihood of malignancy to 1% [122].
Metabolic Tumor Volume (MTV) and Total Lesion Glycolysis (TLG):
Although SUVmax has been linked to prognosis, it represents only
a single highly metabolic focus and it may not accurately reflect
metabolic activity of the whole tumor [123]. The metabolic tumor
volume (MTV) represents the volume of metabolically active tumor
and has been defined as the total number of voxels within a volume
of interest having an uptake above a predetermined SUV threshold
[123,134]. The total lesions glycolysis (TLG) is the product of
the SUVmean and MTV [123,134]. Both MTV and TLG have
been shown to be better indices for patient prognosis [123].
Unfortunately, a standardized SUV threshold has not been defined
for MTV and several thresholds from SUVmax (40% to 50%) or
absolute thresholds, including all voxels with an SUV over 2.5
(TLG2.5), have been suggested [134]. Using these
thresholds, however, can introduce systematic errors- activities
of lesions with a high SUVmax are underestimated by TLG42%,
and the activity of lesions with low activity are underestimated
by TLG2.5 [134].
SUV measurement and respiratory motion: [96]
Respiratory motion produces lesion blurring and an apparent increase in lesion size and speards the lung nodule activity over a larger area [54,95,135]. This results in a decrease in the activity concentration per pixel within the lesion and an underestimation of SUV [54,95]. The degree of lesion motion is dependent on location within the lung (apical lesions will move little, while lower lung lesions can move considerably) [54]. Respiratory motion also degrades PET/CT fusion imaging and max SUV values can vary up to 30% as a result of CT data acquired during different phases of the respiratory cycle [58,62]. Some authors have concluded that SUV max values determined from free-breathing PET/CT imaging are not accurate- particularly for small lesions and lesions located in the lower lung zones [89]. Several methods have been proposed to decrease the effect of respiratory motion:
1- Gating: Improved measurement of lesion volume (decreased
metabolic volume), increased detection of small pulmonary nodules
(improved image quality), and improved quantification of FDG
uptake can be achieved with respiratory gated PET imaging
[54,58,73,95,130]. Gated images have reduced statistical quality,
but have improved spatial resolution and therefore facilitate more
accurate quantification of pulmonary nodules [95]. In one study,
respiratory gating increased the measured SUV max by 22.4% and
tumor volume was decreased by 44.5% [95]. 3D PET acquisition
imaging may be required in order to obtain sufficient counts in
each gate of the PET study [58].
Respiratory gating can be divided into two categories- phase
gating and amplitude gating [96]. In phase gating, each
respiratory cycle is triggered by using a dedicated belt and then
the respiratory cycle is divided into several equal time intervals
(multiple phase ranges) [96,135]. The acquired data are sorted
into each phase range on the basis of their acquisition time
within the respiratory cycle [96,135]. This approach works well
for patients with regular breathing, but errors are introduced in
patients with irregular respiration [96]. Poor synchronization may
either induce rejection of respiratory cycles, resulting in loss
of useful data, or lead to inclusion of inadequate data, resulting
in mixed adequate and inadequate synchronized data and increasing
motion blurring and decreasing image contrast [135].
An amplitude gating technique has been described in which the a
monitoring device determines the respiratory motion amplitude
during the CT scan [96]. The PET scan is then acquired in a
list-mode and a program triggers the PET list-stream whenever the
patient's respiration crossed a present amplitude range as
determined by the CT scan [96]. This technique has the benefit of
not requiring patients to hold their breath and there is no
additional radiation involved with the exam [96]. Using this
technique, the SUVmax can increase by an average of 27% [96]. A
drawback is the longer scan duration required for the list-mode
PET study as only a small portion of the PET data falls within
each preset amplitude range [96].
Newer methods for gating are driven by the measured PET raw data
assessing organ motion rather than body surface motion have been
developed and have been shown to perform favorably [130,131].
2- Inspiration imaging: Another proposed method is to acquire a
deep inspiration breath hold CT and then several breath hold PET
data sets (6 to 9 data sets for 20 second breath holds which are
added together to generate one 2 or 3-minute data set) [82,135]. A
respiratory motion-tracking system permits display of the
breathing amplitude to aid in consistent breath holds- permitting
accurate fusion of the PET and CT data sets [82,89]. About 2/3d's
of lesions will show an increased SUV on breath hold PET imaging
with an average increase of 14% [82]. This method has also been
shown to permit the identification of more lung lesions when
compare to clinical shallow breathing CT [82]. However, the exam
does increase patient radiation exposure due to the second CT exam
and up to 60% of lung cancer patients may not be able to perform
the technique successfully [82,96].
A single breath hold PET acquisition using one second per frame list-mode dynamic data collection until the patient can no longer hold their breath has also been described for inspiratory imaging [89]. A single breath hold 20 second acquisition has also been used- resulting in a significant increase in tumor SUVmax compared to free-breathing PET or respiratory gated PET particularly for small and lower lung lesions (an increase in SUVmax of up to 80% compared to standard imaging) [94,135]. The effective dose to the patient from the additional breath-hold CT scan is between 1.1-1.1 mSv [94], but does have the benefit of improved detection of small nodules [135].. Unfortunately, the technique does not significantly aid in the evaluation of lesions with low baseline FDG accumulation (SUV max <1.5) [94].
Improved detection of malignant lesions has been reported to be obtained by performing dual time point imaging [16,53]. This technique takes advantage of the fact that tracer activity will washout of inflammatory lesions, while malignant lesions retain or increase in FDG activity over time [16,53]. In the study by Matthies et al [53], sensitivity and specificity of a standard SUV measurement greater than 2.5 for malignancy were 80% and 94%, respectively. For dual time imaging, using a threshold of a 10% increase in SUV between the two exams, sensitivity increased to 100% and specificity was 89% [53]. Lesions with a baseline SUV of less than 1.0 have a very high likelihood of being benign and dual time imaging is not required as it may result in false positive exams [53]. Even for nodules with SUV max values of less than 2.5, the dual phase exam may not provide accurate discrimination between benign and malignant lesions (particularly in areas with a high incidence of granulomatous disease as false positive exams have been reported in association with granulomatous inflammation) [88]. A limitation to consider when performing dual time imaging is patient motion which can significantly affect SUV determination, especially for low SUV values. Also- the change in SUV is dependent on reproducibility of the same ROI between both exams [53].
|
Example: The CT scan in this patient demonstrated a small nodule in the left upper lobe (black arrow). PET-FDG images demonstrate very intense accumulation of the tracer within the lesion (white arrow), which was a non-small cell lung cancer. (Case courtesy of H. Page McAdams MD, Department of Radiology, Duke University Medical Center) |
|
|
|
Lung cancer 1 cm lesion: The images below were from a patient with a 1 cm sized right upper lobe lung cancer. Note the excellent conspicuity of the lesion on FDG PET imaging. The exam was acquired using an ECAT EXACT PET scanner (CTI) with 5 min/bed emission and 2 min/bed segmented transmission. OS-EM iterative reconstruction was used for exam reconstruction. Case courtesy of Mallinckrodt Institute of Radiology/ Barnes Hospital, St. Louis and CTI PET Systems, Inc. |
|
|
|
True negative PET scan: The patient in the scan below had a 1.5 cm left upper lobe nodule (shown below) that could be retrospectively identified on a prior CT scan at which time it measured only 4 mm. A PET scan was performed (below right), but demonstrated no uptake in the lesion (some cardiac activity can be seen more anteriorly). Because the nodule had enlarged from a prior exam, the nodule was resected and found to be a granuloma. Nodules larger than 1.5 cm that are negative on PET scans have a highly likelihood for representing benign or indolent lesions. |
|
|
False positive results are not uncommon and can be seen with pneumonia [59], infectious granulomas (tuberculosis, histoplasmosis, aspergillosis, cryptococcus, and inflammatory pseudotumor) [36,50,59] or inflammatory processes (sarcoid [59], Wegener's), rheumatoid nodules [13,15], cryptogenic organizing pneumonia (BOOP) [63], nodular pulmonary amyloidosis [59], and an aggressive neurofibroma [8]. Progressive massive fibrosis in silicosis can be markedly positive (likely because of inflammatory cell activity) and cannot be reliably distinguished from lung cancer [63,74]. False positive lung nodule exams are thought to be related to increased glycolytic activity within activated macrophages [3]. Talc pleurodesis also creates a chronic granulomatous reaction which can have increased FDG uptake [59].
|
False positive PET scan: The patient below had a right middle lobe nodule detected incidentally during abdominal CT scanning. The nodule demonstrated increased FDG uptake on PET imaging. Due to a history of chemical exposure and second hand smoke inhalation the nodule was resected and found to be a granuloma. |
|
|
Although uncommon, false negative exams can occur. It should be noted that the long term survival of patients with a false-negative PET scan for lung cancer suggests that these tumor behave in an indolent manner [65]. False negative exams tend to occur in four settings [41,73].
1- A neoplasm with low metabolic activity: Bronchoalveolar cell carcinoma (BAC) may have a lower uptake value and can cause a false-negative result in up to 57% of cases [18,21,47,50,60] (in one article 81% of pure BAC lesions had SUV max values less than 2.5 [90]). Interestingly, Thallium-201 imaging is more commonly positive for BAC [1]. Because bronchoalveolar cell carcinoma is often PET-negative, PET scans should be discouraged if a nodule is predominantly ground-glass [67]. Another pulmonary neoplasm which frequently has a negative FDG PET exam (SUR < 2.5) is a carcinoid tumor (reported sensitivity between 14-75%) [42,43,50,60,80]. Atypical carcinoids and those presenting as solitary pulmonary nodules are somewhat more likely to be positive on PET imaging [80]. Mucoepidermoid carcinomas may show little FDG uptake [74]. Although less common, other NSCLC's (particularly well differentiated adenocarcinomas and less commonly squamous cell carcinoma) may also fail to demonstrate significant FDG accumulation [38,47,60]. With the exception of BAC and carcinoid, lung cancers with false-negative PET scans are usually early stage or low malignant potential lesions with an overall favorable prognosis [60]. Indeterminate pulmonary nodules which are negative on FDG PET imaging can be managed conservatively with serial CT evaluation to assess for signs of growth [60].
|
Bronchoalveolar cell carcinoma (BAC): The images below were from a patient with bronchoalveolar cell carcinoma that presented as a chronic right lung infiltrate. The FDG PET exam was positive in this case despite a higher likelihood of a false negative exams in patients with BAC. Note the most intense area of FDG accumulation corresponds to the area of greatest consolidation on CT imaging. |
|
|
|
Atypical carcinoid tumor: The patient presented for evaluation of a right lung nodule. The nodule was positive on PET imaging and was surgically resected. The nodule proved to be an atypical carcinoid tumor. Most carcinoids are not positive on PET imaging, however, atypical carcinoids are more aggressive lesions and this may explain the FDG accumulation. Unfortunately, the patient had ipsilateral hilar lymph node metastatses which were not seen on CT or on PET imaging. |
|
|
2- Small lesions (under 1 cm to 1.5 cm in size) or lesions with a physically small histologic complement of malignant cells: Lesions as small as 1 cm can be accurately evaluated, but the evaluation of smaller lesions may result in false negative results due to spatial resolution limitations of PET imaging and respiratory motion [7,13,21]. False negative PET scans can be seen in up to 27% of lesions 1 cm or smaller in size [67]. This error rate decreases to 10% for lesions between 1-2 cm in size [67].
Another fact to remember is that the measured SUV underestimates the true metabolic activity of a lesion when its size is less than twice the spatial resolution of the camera (which is approximately 5 mm for a PET camera) [7,13,21,66]. Simply stated, the measured activity in a small volume of a PET image will not exactly represent the real value, but depends on the activity in the neighboring voxels (this is termed the partial volume effect or spillover) [97]. For a lesion 1.5 times the spatial resolution of the camera, measured maximal activity is only 60% of the true maximal activity [73]. FDG PET has shown a decreased sensitivity (80%) for malignancy for lesions smaller than 1.5 cm [41,47]. The ability to characterize smaller lesions is in part dependent on the degree of tracer accumulation within the lesion. Even very small lesions can be correctly characterized if they accumulate enough FDG to become visible. Sensitivity for lesions between 5-8 mm in size is between 50% to 73% [7,41].
|
Small nodule: The patient shown below presented for evaluation of an 8 mm right lower lobe pulmonary nodule (white arrow). The PET scan was negative, but because of the lesions small size, the lack of uptake is not definitive for a benign lesion. Follow-up CT imaging will be required to document that the lesion remains stable over time. |
|
|
3- Hyperglycemia [47]: Competitive inhibition from high serum glucose levels appears to hinder FDG uptake in some cases. This effect is most important with acute hyperglycemia while a chronically raised glucose level inhibits tumor uptake minimally (about 10%) [41].
|
Chronic hyperglycemia:
The patient below presented for staging of a left lung
non-small cell lung cancer. The patient was a diabetic
and had a blood glucose of 206. Because of social
issues, it was elected to inject the patient and
perform the scan. The images obtained were of
excellent quality with marked uptake in the patients
left lung mass (blue arrow). Also, several less than 1
cm lymph nodes in the aorto-pulmonary window and
mediastinum were positive on the PET exam (black
arrows) and these had not been called prospectively on
the CT study. The patients chronic hyperglycem |
|
|
4- Ground-glass nodules: Ground glass nodules associated with malignancy are typically bronchoalveolar cell carcinomas [73,108]. Low sensitivity (10%) and specificity (20%) have been reported for FDG PET imaging in the evaluation of ground glass nodules [73]. Another study demonstrated tracer uptake in only 24% of BAC's with a mean SUV max of 1.8 (+/- 1.0) [108]. In that same study, 69% of adenocarcinomas with BAC components were PET positive (mean SUV max 2.9 +/- 1.1 [108]. Studies have shown that SUVmax of GGNs positively correlates with the total lesion size, the CT attenuation, and the size of the solid components [138]. Lesions with a larger percentage of ground-glass component are more likely to be negative on PET [108]. As such, there is probably little utility in the evaluation of ground glass nodules with PET imaging [73] and no clear advantage for staging due to low tumor uptake and the low incidence of nodal and distant metastasis in the cases [108].
Based upon the present data available- a lesion that is hot on PET should be considered malignant until proven otherwise. A lesion that is PET negative has a low probability for being a malignancy (under 5% [37,66]). However, one must consider all characteristics of a lesion prior to discounting its malignant potential. Follow-up exams should be performed on PET negative nodules to ensure stability [37]. If the lesion grows, further evaluation with tissue diagnosis should be obtained [37]. Patients who have a negative FDG PET exam but are subsequently shown to have lung cancer may have an overall better survival compared to patients with positive FDG exams [7].
Nuclear medicine gamma cameras equipped with ultrahigh energy collimators have also been used to perform SPECT images of 18-FDG in patients with suspected lung cancer. Overall sensitivity of SPECT FDG is 77% to 81% for identifying malignant pulmonary lesions (sensitivity has been report to be 100% for lesions larger than 2 cm [24]). Specificity is 91-100%. Small malignancies (less than 2 cm in size) are not reliably characterized with this imaging technique (sensitivity for lesions less than 2 cm is only 20-50%). The small number of patients studied and the high incidence of malignancy in the study groups (60-75%) make any conclusions about the true sensitivity of SPECT 18-FDG premature. [10]
Nuclear medicine dual detector gamma cameras have also been modified to permit coincidence detection. In general, these cameras have a limited intrinsic detector efficiency for the high energy FDG emissions which results in poor counting statistics. Non-true coincidence detection also contributes to image noise. None-the-less, pulmonary lesions larger than 2 cm seem to be well detected due to the relatively low background activity of the lungs. Lesions within the deep mediastinum and abdomen less than 1.5 cm in size, are less well identified [19]. However, despite technical improvements lesion detectability using hybrid gamma cameras is still limited compared to dedicated PET scanners [4].
Tumor progression during first line chemotherapy occurs in about 30% of patients with advanced stage non-small cell lung cancer [85]. Most treatments have associated toxic side effects. Therefore, an accurate assessment of the efficacy of chemotherapy and radiation therapy would prove of enormous value in directing therapy for patients with advanced stage NSCLC [45]. Early identification of non-responders would permit a shift to second or third-line treatments and minimize the toxicity of ineffective therapy [93].
On conventional imaging, a tumor response is defined as a therapy-induced reduction in the largest dimension of the tumor by 30% [73]. However, measuring the morphologic response to treatment is less than ideal as changes may take weeks to months to appreciate and therapy induced peritumoral scarring can mask tumor regression [73]. PET FDG imaging can better evaluate the effectiveness of treatment and can also provide prognostic information regarding patient outcome following initiation of therapy [29]. In fact, FDG PET exam findings may be a better predictor of survival than WHO criteria [69].
Most studies support that chemotherapy induced changes in tumor
glucose metabolism (as determined by FDG PET) is highly predictive
of patient outcome- allowing stratification of overall survival
and progression free survival [85,93]. Normalization of FDG uptake
(i.e.: no uptake) after treatment indicates a good response to
therapy and appears to be a good prognostic indicator [41,45].
Preliminary data also indicate that patients with positive PET
scans following initial lung cancer therapy have a significantly
worse prognosis than patients with negative results [11,29].
In one study, all patients with negative PET exams following
treatment were alive at two years (even in the presence of
non-specific radiologic changes), while 50% of patients with
residual hypermetabolism had died during the same two year period
[41,45]. In another study, a reduction in FDG activity of 20% (by
SUV analysis) after one cycle of chemotherapy was associated with
a 1 year survival rate of 44%, compared to only a 10% survival
rate for tumors that did not respond [69]. Early imaging following
the institution of therapy has also been shown to provide
prognostic information [83]. A 50% decrease in SUV between scans
performed at 1 and 3 weeks following initiation of chemotherapy
can predict a favorable response [83]. Patients that do not
demonstrate an early significant decrease in SUV have a poor
prognosis [83]. By identifying responders early, unnecessary
chemotherapy can be discontinued and alternative treatment methods
instituted [83]. SUVmax and SUVpeak values have been shown to have
inherent variability when the same patient is imaged twice on two
separate days- typically 10-15%, but higher variation has been
reported in lung cancers [126]. As a result, a decrease in FDG
uptake by 30% or more is likely reflective of a metabolic
response, and an increase of more than 40% is suggestive of
metabolic progression [126].
Because of the limitations of SUV max (influence by image noise
and lack of ability to accurately reflect tumor heterogeneity)
other quantitative PET parameters have been developed and
may be better at predicting tumor response [117]. The metabolic
active tumor volume (MTV) is defined as the total volume of tumor
that falls above a defined percentage of the maximum activity
(typically the 50-60% isocontour) [117]. The total lesion
glycolysis (TLG) is defined as the sum of the SUV x MTV (cm3)
for all tumor sites [117]. Change in TLG and MTV have been shown
to be predictive of early therapy response in patients with
locally advanced NSCLC [117,121]. Tumor volume and total lesion
glycolysis have been shown to correlate with the amount of
residual viable tumor following induction chemotherapy in patients
with locally advanced NSCLC [120]. MTV and TLG have also
been shown to correlate with prognosis. In one study, a decrease
of over 30% in MTV on early post treatment PET/CT was associated
with a statistically significant survival benefit [121]. For
patients with Stage IIIA-N2 non-small cell lung cancer, a higher
pretreatment MTV (>22 cm3) is associated with an
overall worse prognosis [128]. Another study demonstrated that a
high TLG of the primary lesion in non-small cell lung cancer is
associated with a poor long term clinical response and disease
specific survival in patients receiving definitive XRT [137].
In comparing semiquantitative response assessments versus visual
qualitative assessment, one study found that visual criteria has
better interobserver agreement and stronger discrimination for
complete metabolic response [136].
A 5-point qualitative therapy response assessment (Hopkins
criteria for lung cancer) has been shown to have high
interinterpreter agreement and high sensitivity (89%), specificity
(80%), PPV (93%), NPV (71%), and accuracy (87%) [129].
The 5-point Hopkins criteria scale is [129,139]:
1- Uptake less than mediastinal blood pool consistent with complete response
2- Uptake greater than mediastinal BP, but less than the liver consistent with likely complete metabolic response
3- Diffuse uptake above mediastinal BP or liver consistent with probable inflammation
4- Focal uptake greater than the liver consistent with likely residual disease
5- Focal intense uptake consistent with residual disease [129].
Any uptake from 1 to 3 is considered negative and uptake of 4 or
5 is considered positive [129]. Patients with visually positive
scans have been shown to have decreased overall survival compared
to those with negative scans [129].
Further evaluation will be required to determine if changes in therapeutic regimens should be made based upon positive PET FDG results after first-line treatment. Also, a decrease in FDG uptake may only indicate a partial response to treatment resulting from destruction of sensitive cells, while resistant cells continue to be metabolically active [41,45].
Unreliable outcome prediction on end-of-treatment FDG PET scans
is most likely caused by post radiation therapy changes [117].
Radiation therapy can result in inflammatory changes (accumulation
of macrophages, neutrophils, fibroblasts, and granulation tissue)
that may be difficult to differentiate from recurrent tumor [61].
This uptake is most intense in the first 6 months after therapy
[61]. In-treatment scans performed as early as 2 weeks post-XRT
more likely reflect a true metabolic tumor effect as the
inflammatory changes associated with XRT have not yet occurred
[117].
On late post-therapy scanning, radiation generally produces a
diffuse, mildly elevated FDG accumulation within the tissues
included in the radiation port [41]. This activity should decrease
over time and scans are more reliable when obtained at least 12
weeks after completion of XRT (although a longer wait is more
desirable if possible as inflammatory changes can sometimes
persist for up to 15 months following treatment) [55,132]. Scans
will be most reliable when a year or more has passed from the last
radiation treatment [41]- still, uptake within the radiation port
must be interpreted with caution [61]. A SUR of 2.5 still appears
to be accurate in differentiating benign changes from tumor [41].
In a study evaluating changes in FDG uptake following definitive
XRT, patients with higher residual SUVmax in the primary tumor
(cutoff 3.7) or lymph nodes (cutoff 3.1), had a worse prognosis
[109]. This study also found that the greater the reduction in the
single target lesion with the highest pretherapy SUVmax, the
greater the overall survival - a reduction of 72% or more in the
highest target lesion was associated with better overall survival
[109]. Interestingly, this study did not observe a relationship
between pretreatment SUVmax and survival, only post XRT SUVmax or
the extent of redution in SUVmax predicted survival [109]. Early
PET imaging during radiation therapy (after 2nd week of treatment)
has also been shown to correate with patient response and
prognosis [114].
Kinase inhibitors targeting the epidermal growth factor receptor
(EGFR) can improve progression free survival and overall survival
in some patients with non-small cell lung cancer [106]. PET/CT
imaging performed early (1-2 weeks) following the start of therapy
can be used to identify responders from nonresponders
[106,107,110].
|
Response to treatment: 58 year old male with a left upper lobe non-small cell lung cancer and contralateral right hilar lymphadenopathy (blue arrow). FDG imaging also identified uptake in the inferolateral aspect of the right hemithorax which most likely represented a pleural metastasis with probable chest wall/rib invasion (black arrow). Because of the advanced stage of disease, the patient received radiation and chemotherapy. Follow-up PET FDG imaging demonstrated decreased tracer uptake and decreased size of the primary lesion in the left upper lobe (red arrow). The metastates in the right hilum, as well as the right pleura or chest wall have virtually resolved. Unfortunately, despite a positive response to treatment the presence of residual FDG activity in this patient would indicate a long term poor prognosis. Case courtesy of the North Texas Clinical PET Institute and CTI. |
|
|
|
Non-small cell lung cancer response to therapy: The patient shown below had widely metastatic left lower lobe lung cancer to mediastinal nodes, bones (left humerus), liver, and multiple pulmonary nodules. Note the dramatic improvement in the patient's post therapy scan (shown below). Click images to view rotating avi files. |
|
|
PET findings following percutaneous radiofrequency ablation:
Percutaneous radiofrequency ablation may offer an alternative for patients that are not surgical candidates or those with unresectable tumors and is generally well tolerated. The benefits of this technique include preservation of more lung tissue and a reduction in morbidity compared to surgical resection [100]. Smaller lesions (less than 3 cm) are more likely to have demonstrate complete necrosis following therapy which is associated with a better long term survival [99]. RFA of stage I non-small cell lung cancer has 78% one-year and 27% 5-year survival rate [104].
Expected changes on CT following ablation of a lung mass include cavitations, bubble-shaped areas of lucency, pleural thickening, and adjacent areas of ground-glass opacity [103]. There can also be an apparent increase in size of the lesion that can persist for some time [103]. If the ablation was successful, eventually the lesions appear as low-attenuation areas with complete lack of contrast enhancement consistent with necrosis [100,101]. Partially ablated lesions show various enhancement patterns [100]. Reactive hyperemia in the tissue surrounding the ablated lesion represents an inflammatory reaction to the thermal injury and this can be seen on studies performed shortly after therapy [100]. A thin symmetric rim of peripheral enhancement of less than 5 mm width can be seen for up to 6 months after ablation [101]. Irregular focal enhancement of more than 15 HU compared with an unenhanced exam is considered evidence of local tumor progression [101].
Ideally, a baseline PET exam should be performed prior to RFA treatment to document lesion uptake [103]. Additonally, PET imaging prior to planned RF ablation can result in a change in patient management in up to 28% of patients due to upstaging and detection of unsuspected metastatic disease [102]. PET findings suggestive of local recurrence following RFA may precede CT findings by 6 months or more [99,102]. Early detection of recurrence after ablation is critical as repeat ablation for salvage is most effective when the tumor is small [99].
Because post-ablation inflammation can mask residual tumor, PET
imaging is typically delayed until 2 months following RFA [112].
Early (a few days to 1-4 months) following ablation, mild diffuse,
heterogeneous, or mild homogeneous rim-like tracer uptake can be
seen and may reflect normal post ablation inflammatory changes
[99,103] (although other authors feel that heterogeneous uptake is
concerning for incomplete treatment and that mild heterogeneous
uptake is equivocal and should be followed-up [102]).
When using PET imaging to evaluate for response following RFA,
both the degree of tracer uptake and the pattern of tracer
distribution should be used to evaluate effectiveness of the
therapy [99]. Complete absence of tracer uptake in the lesion is
consistent with successful ablation and this can be seen on PET
imaging obtained immediately following the RFA [102,103]. Tissue
regeneration and inflammation in the periphery of the necrotic
zone are seen as early as 2-3 days following RFA and these changes
are shown to be associated with increased FDG uptake [103].
Inflammatory activity can potentially mask foci of residual
disease [103]. Ideally, PET imaging should be performed
approximately 24 hours following the procedure to decrease uptake
associated with post-Rx inflammation [103]. Additionally, early
PET imaging can readily detect any residual tumor and permit rapid
re-treatment[103]. However, 6 month post procedure PET/CT has
better correlation with clinical outcome at one year, compared to
early (4 day) post ablation imaging [104].
Unfavorable patterns of tracer uptake concerning for residual or recurrent tumor include a discrete focal area of uptake or a rim of activity with a persistent focal area of uptake in the same location as the original tumor nodule [99,104].
Studies have suggested that local tumor regrowth is more likely when the reduction in SUV is less than 60% from baseline at 2 months following RFA [99]. Persistent focal uptake with an SUVmax>2.5, an increase in SUV max of at least 25% on serial follow-up post -Rx PET imaging, or an increase in the extent of FDG uptake is concerning for recurrence [102]. Uptake in reactive mediastinal lymph nodes can be seen in up to 15% of patients at 3 months following ablation and also at the needle path puncture site [102].
Recurrent Lung cancer: Differentiating Scar/Fibrosis from Recurrent Neoplasm:
Although no conclusive data support the use of any therapies in relapsed lung cancer, some patients with localized disease can be cured with aggressive therapy [2]. A major problem in the follow-up evaluation of patients treated for lung cancer is distinguishing post-treatment changes from recurrent tumor [48]. Presently, tumor recurrence is often not diagnosed until the disease has progressed to the point of marked enlargement of questionable abnormalities [41]. PET FDG imaging is very sensitive and highly accurate in distinguishing recurrent malignancy from scarring/fibrosis [13,41,48,49]. FDG PET imaging has been shown to have a sensitivity 98-100% for the differentiation of post-treatment change from tumor recurrence [48]. In a prospective evaluation of patients treated for NSCLC [48], FDG PET was able to correctly identify recurrent disease in all patients (sensitivity 100%) [48]. In this same group, CT imaging was non-contributory in 28% of cases at the time of FDG PET diagnosis [48]. With regards to post-surgical patients, the inflammation from surgery resolves relatively quickly (typically within 6 weeks) [81].
Hicks et al also evaluated FDG PET in patients with suspected recurrent non-small cell lung cancer [2]. PET exams were positive in 41 of 42 patients with confirmed relapse (sensitivity 98%) [2]. The PET exam was negative in 14 of 17 patients with no evidence of relapse (specificity 82%), while CT was abnormal in 15 of these 17 patients (specificity 12%). Overall, CT was correct in identifying disease extent in 24% of patients, while PET was correct in 86% [2]. PET findings affected patient management in 63% of cases [2]. Patients with a positive PET exam had a poorer prognosis compared to patients with a negative study [2]. PET/CT has been shown to be superior to PET for the evaluation of suspected recurrent lung cancer secondary to improved anatomic localization of suspicious findings [64].
False positive exams can occur in association with infection and radiation pneumonitis [48]. Positive FDG PET exams due to radiation pneumonitis can be seen in up to 4% of patients receiving XRT therapy. The abnormality is usually diffuse, involves the lung and pleura, and conforms to the radiation port [2]. The duration of abnormality associated with radiation pneumonitis is variable and exams can remain positive (SUV greater than 2.5) for 6 to 15 months [48]. FDG PET findings associated with radiation pneumonitis should show decreased activity over time [48]. It is probably best not to perform FDG PET imaging earlier than 2-6 months after XRT in order to reduce the likelihood of false-positive PET results [48,81]. However, the inflammatory effects of radiation can last more than one year [81].
FDG-PET can also assist in identifying hypermetabolic foci within radiographic abnormalities to better direct tissue biopsy [45].
Screening for recurrence is another potential use of FDG PET imaging [48]. In a group of patients with NSCLC treated for cure, FDG PET screening was able to document the presence of recurrent tumor in all patients, whereas the finding was missed by CT in 44% [48]. If detected sooner, retreatment could be instituted in an effort to obtain prolonged disease control [48]. Further studies will be required to determine if improved detection of recurrent on FDG PET screening can result in improved patient survival [48].
Among patients with resected non-small cell lung cancer (NSCLC) between 30% to 50% will develop recurrent tumor [6]. The TMN staging system provides some insight into overall patient prognosis, but fails to explain differences in survival among patients with similar staged lesions. Evaluation of tumor molecular biology has provided a greater understanding of why certain tumors are more likely to recur and insight into tumor treatment response. In patients with NSCLC, measurements of tumor proliferation estimated by proliferating cell nuclear antigen (PCNA) and Ki-67 expression have prognostic value for recurrence and survival [6]. Increased PCNA and Ki-67 expression are associated with a poor outcome [6]. The tyrosine kinase domain of the EGFR gene has been found to predict sensitivity to EGFR kinase inhibitors such as gefitinib (Iressa) and erlotinib (Tarceva) in the patient subpopulation of adenocarcinoma histology, absence of smoking history, female sex, and East Asian ethnicity [93]. The presence of K-ras mutations is associated with resistance to these drugs [93].
FDG uptake in NSCLC has also been correlated with tumor growth
rate, aggressiveness, and proliferation capacity [6]. FDG uptake
has been identified as an independent prognostic factor correlated
with survival in patients with lung cancer- particularly early
stage lesions [6]. Varying SUV cut-offs have been determined
to select patients with the greatest risk for recurrence [6]. In
one study, a preoperative maximum SUV of 5.5 or higher was found
to be an independent predictor of relapse and death in patients
with resected stage I NSCLC [92]. Essentially, the higher the SUV,
the higher the proliferation capacity (aggressiveness) of the
tumor and the worse the prognosis [6,73].
However, SUV max may not be the best predictor of prognosis
because SUV max represents a single pixel value that may be
subject to variability, it may be a less reliable predictor of
outcome compared to other measurements such as total metabolic
tumor volume (which can be defined by a specific threshold of SUV
max) [116]. The total metabolic tumor volume (MTV) has been shown
to have a better correlation with survival and prognosis
[116,118]. Total lesion glycolysis (TLG) which represents the MTV
multiplied by the average SUV (defined by using a fixed threshold
of the maximum intratumoral activity) [118]. TLG has also been
shown to have a strong correlation with prognosis [118]. There is
also increasing recognition that the spatial heterogeneity of 18F-FDG
uptake in the tumor can indicate an increased risk for nonresponse
to chemoradiotherapy and be associated with a poor prognosis
[115]. It has been postulated that intratumoral heterogeneity is
associated with regional tumor cellularity, proliferation,
hypoxia, angiogenesis, and necrosis- factors associated with more
aggressive behavior [127]. Areas of high FDG uptake on
pretreatment PET/CT scans also identify tumor sub-volumes at
greater risk of relapse following treatment with chemoradiation
[124]. The tumor sub-volumes with an SUV > 50-70% of the
maximum SUV have the highest risk for relapse and targeting these
regions for more aggressive radiation therapy may provide a
survival benefit [124].
Additionally, it has been suggested that the presence of positive
mediastinal nodes at preoperative PET (determine by qualitative
assessment compared to the mediastinal blood pool), despite the
LN's being negative at histologic analysis, carries adverse
prognostic implications with an increased risk for local and
distance disease recurrence [105]. This may be related to
false-negative mediastinoscopy performed undering staging (overall
false-negative rate is 11%) [105].
Generalized bone marrow hypermetabolism characterized by diffuse
increased axial skeletal FDG uptake has also been described in
untreated patients with small cell lung cancer and is associated
with an increased risk of mortality [75]. The etiology of the
skeletal uptake is uncertain, but may be related to secretion of
stimulating cytokines by the tumor, micrometastatic disease to the
bone marrow, or host factors such as PaO2 or hemoglobin
levels [75].
Radiation therapy:
FDG PET imaging can also provide important information with regards to radiation therapy planning [57]. Biologic targeting with PET can alter the planned radiation treatment volume in 30-60% of patients with non-small cell lung cancer [57]. Generally, the PET findings enlarge the planned treatment volume determined by CT alone [57] and 40% of the SUV max has been used to delineate the gross tumor volume on PET imaging [78]. However, studies indicate that PET threshold will likely need to be individualized on the basis of tumor size, location, non-uniform activity, and status of breathing control [78]. PET can also aid in demarcation of the tumor from adjacent atelectasis which will decrease the treatment portal [57]. Targeting the more metabolically active portions of the tumor with additional radiation is another benefit of the incorporation of the PET findings into the treatment plan. Long-term studies will be required to determine if the additional information provided by the PET exam results in improved patient survival [57].
Tumor motion secondary to ventilation also poses a problem for XRT of NSCLC [57]. Lower lobe lesions can move as much as 3 cm in the z-axis with respiration [57]. There are three methods to account for this tumor motion when planning therapy: 1- fuse inspiratory and expiratory CT images to incorporate the movement; 2- gate the linear accelerator to specific phases of the respiratory cycle; 3- or incorporate breath hold maneuvers during therapy [57]. With PET, the images are acquired over several minutes and thus the PET tumor volume should account for tumor excursion [57].
When performing PET for purposes of radiation planning, proper
patient positioning is very important [57]. A flat table insert
and use of immobilizing devices used for XRT planning aid in
proper co-registration [57].
In followup management:
In one study, 18F FDG PET/CT
surveillance performed more than 6 months (median 29 months)
after the completion of primary treatment can identify
unsuspected recurrence in up to 44% of patients [119]. In
another study, surveillance PET resulted in a change in patient
management in up to 42% of patients [119]. Overall survival is
decreased in patients under the age of 70 years with positive
surveillance PET scans compared to patients with negative
studies [119].
Presently, CMMS has ruled that only 3
posttherapy PET scans will be funded for reimbursement, and that
any additional followup scans will be funded at the discretion
of the local Medicare administrator [125]. However, the fourth
and subsequent scans have been shown to detect recurrence in up
to 44% of scans performed without prior clinical suspicion of
recurrence, can rule out recurrence in 24% of scans, and can
change management in up to 28% of cases [125].
In Small Cell Lung Cancer:
Small cell lung cancer is considered to be the most aggressive form of lung cancer. It accounts for 18-25% of cases of lung cancer [73]. Small cell cancer has a high proliferation rate which results in avid FDG uptake [56]. At presentation patients are either considered to have limited disease (LD) or extensive disease (ED) [56]. Limited disease is defined as disease confined to one hemithorax and regional lymph nodes which can be targeted with a single radiation port field [56]. Disease which has extended outside the thorax or the presence of a malignant pleural effusion is considered extensive disease [56]. At presentation, about 30-40% of patients have LD, while 60-70% present with ED [56].
Treatment is based upon the extent of disease. Selected patients with very limited stage disease (T1-2 lesion and no lymph node metastatses) may be treated with surgical resection [56]. Patients with LD are treated with a combination of chemotherapy and chest radiation [56]. Patients with ED receive chemotherapy [56]. Accurate pretreatment evaluation is essential for determining optimal therapy.
PET imaging can be useful for initial tumor staging and in treatment planning for patients with presumed limited disease [70]. Preliminary work has shown that FDG PET imaging can have a significant impact on patient management [56,98]. PET imaging findings can change management in up to 37% of patients for initial staging and in up to 15% of patients for restaging [56]. PET findings can result in changes in the planned radiation field and in the detection of unsuspected sites of disease [56]. PET is also highly accurate for identifying patients in complete remission following therapy [56]. PET imaging is limited in the assessment of CNS disease in patients with small cell lung cancer [56]. MRI is the most sensitive means to exclude brain metastases [56]. PET imaging can also provide prognostic information- a high maximum SUV suggests shortened survival [84].
REFERENCES:
(1) J Nucl Med 2001; Higashi K, et al. Comparison of [18F]FDG PET and 201Tl SPECT in evaluation of pulmonary nodules. 42: 1489-1496
(2) J Nucl Med 2001; Hicks RJ, et al. The utility of 18F-FDG PET for suspected recurrent non-small cell lung cancer after potentially curative therapy: impact in management and prognostic stratification. 42: 1605-1613
(3) Radiol Clin N Am 2001; Hagge RJ, et al. Positron emission tomography. Brain tumors and lung cancer. 39: 871-881
(4) Radiol Clin N Am 2001; Delbeke D, Martin WH. Positron emission tomography in oncology. 39: 883-917
(5) AJR1995; Kaiser LR, Shrager JB. Video-assisted thoracic surgery: the current state of the art. 165: 1111-1117
(6) J Nucl Med 2002; Higashi K, et al. 18F-FDG uptake as a biologic prognostic factor for recurrence in patients with surgically resected non-small cell lung cancer. 43: 39-45
(7) Radiology 2002; Marom EM, et al. T1 lung cancers: sensitivity of diagnosis with fluorodeoxyglucose PET. 223: 453-459
(8) Radiology 1997; 202: 435-439
(11) J Nucl Med 2003; Kostakoglu L, Goldsmith SJ. 18F-FDG PET evaluation of the response to therapy for lymphoma and for breast, lung, and colorectal carcinoma. 44: 224-239
(13) RadioGraphics 1998; Frasmus JJ, et al. Thoracic FDG PET: state of the art.18: 5-20
(15) J Nucl Med 1998; 39: 234-236
(16) J Nucl Med 2003; Demura Y, et al. 18F-FDG accumulation with PET for differentiation between benign and malignant lesions in the thorax. 44: 540-548
(21) J Nucl Med 1998; Higashi K, et al. Fluorine-18-FDG PET imaging is negative in bronchoalveolar cell carcinoma. 39: 1016-1020
(24) Chest 1999; Mastin ST, et al. FDG SPECT in patients with lung masses. 115: 1012-1017
(25) J Nucl Med 1999; Coleman RE. PET in lung cancer. 40: 814-820
(29) AJR 2000; Patz EF, et al. Prognostic value of thoracic FDG PET imaging after treatment for non-small cell lung cancer. 174: 769-774
(36) Radiology 2000; Goo JM, et al. Pulmonary tuberculoma evaluated by means of FDG PET: Findings in 10 cases. 216: 117-121
(37) Radiographics 2000; Patz EF. Evaluation of focal pulmonary abnormalities with FDG PET. 20: 1182-1185 (No abstract available)
(38) N Engl J Med 2000; Pieterman RM, et al. Preoperative staging of non-small-cell lung cancer with positron-emission tomography. 343: 254-261
(39) AJR 2000; Boiselle PM, et al. Lung cancer detection in the 21st century: Potential contributions and challenges of emerging technologies. 175: 1215-1221 (No abstract available)
(40) Chest 2000; McCain TW, et al. The usefulness of positron emission tomography in evaluating patients for pulmonary malignancies. 118: 1610-1615
(41) Thorax 1998; Lowe VJ, Naunheim KS. Current role of positron emission tomography in thoracic oncology. 53: 703-712
(42) Radiographics 1999; Rosado de Christenson ML, et al. Thoracic carcinoids: Radiologic-Pathologic correlation. From the archives of the AFIP. 19: 707-736
(43) AJR 1998; Erasmus JJ, et al. Evaluation of primary pulmonary carcinoid tumors using FDG PET. 170: 1369-1373
(44) J Nucl Med 1999; Delbeke D. Oncological applications of FDG PET imaging: Brain tumors, colorectal cancer, lymphoma, and melanoma. 40: 591-603
(45) Ann Thorac Surg 1998; Lowe VJ, Naunheim KS. Positron emission tomography in lung cancer. 65: 1821-29
(46) J Nucl Med 2001; Avril N, et al. Glucose metabolism of breast cancer assessed by 18F-FDG PET: Histologic and immunohistochemical tissue analysis. 42: 9-16
(47) J Clin Oncol 1998; Lowe VJ, et al. Prospective investigation of positron emission tomography in lung nodules. 16: 1075-84
(48) Eur Respir J 1999; Bury T, et al. Value of FDG-PET in detecting residual or recurrent nonsmall cell lung cancer. 14: 1376-1380
(49) J Clin Oncol 2001; Kalff V, et al. Clinical impact of 18F fluorodeoxyglucose positron emission tomography in patients with non-small-cell lung cancer: A prospective study. 19: 111-118
(50) Chest 2001; Dunagan DP, et al. Staging by positron emission tomography predicts survival in patients with non-small cell lung cancer. 119: 333-339
(51) Chest 2001; Hauber HP, et al. Positron emission tomography in the staging of small-cell lung cancer. A preliminary study. 119: 950-954
(52) J Cancer Res Clin Oncol 2000; Ilknur AK, et al. Positron emission tomography with 2-[18F] fluoro-2-deoxy-D-glucose in oncology: Part II: The clinical value in detecting and staging primary tumours. 126: 560-574
(53) J Nucl Med 2002; Matthies A, et al. Dual time point 18F-FDG PET for the evaluation of pulmonary nodules. 43: 871-875
(54) J Nucl Med 2002; Nehmeh SA, et al. Effect of respiratory gating on quantifying PET images of lung cancer. 43: 876-881
(55) Radiographics 2003; Kostakoglu L, et al. Clinical role of FDG PET in evaluation of cancer patients. 23: 315-340
(56) J Nucl Med 2003; Kamel EM, et al. Whole-body 18F-FDG PET improves the management of patients with small cell lung cancer. 44: 1911-1917
(57) J Nucl Med 2004; Bradley JD, et al. Implementing biologic target volumes in radiation treatment planning for non-small cell lung cancer. 45 (Suppl): 96S-101S
(58) J Nucl Med 2004; Boucher L, et al. Respiratory gating for 3-dimensional PET of the thorax: feasibility and initial results. 45: 214-219
(59) AJR 2004; Asad S, et al. False-positive FDG positron emission tomography uptake in nonmalignant chest abnormalities. 182: 983-989
(60) AJR 2004; Cheran SK, et al. False-negative findings for primary lung tumors on FDG positron emission tomography: staging and prognostic implications. 182: 1129-1132
(61) Radiology 2004; Rohren EM, et al. Clinical applications of PET in oncology. 231: 305-332
(62) J Nucl Med 2004; Erdi YE, et al. The C motion quantitation of lung lesions and its impact on PET-measured SUVs. 45: 1287-1292
(63) AJR 2004; Kavanagh PV, et al. Nonneoplastic diseases in the chest showing increased activity on FDG PET. 183: 1133-1141
(64) J Nucl Med 2004; Keidar Z, et al. PET/CT using 18F-FDG in suspected lung cancer recurrence: diagnostic value and impact on patient management. 45: 1640-1646
(65) Radiographics 2004; Lee KS, et al. T1 non-small cell lung cancer: imaging and histopathologic findings and their prognostic implications. 24: 1617-1636
(66) Radiol Clin N Am 2005; Mavi A, et al. Fluorodeoxyglucose-PET in characterizing solitary pulmonary nodules, assessing pleural diseases, and the initial staging, restaging, therapy planning, and monitoring response of lung cancer. 43: 1-21
(67) AJR 2005; Lindell RM, et al. Lung cancer screening experience: a retrospective review of PET in 22 non-small cell lung carcinomas detected on screening CT in a high-risk population. 185: 126-131
(68) Radiol Clin N Am 2005; Goldsmith SJ, et al. Radionuclide imaging of thoracic malignancies. 43: 571-588
(69) Radiology 2005; Munden RF, et al. Imaging of the patient with non-small cell lung cancer. 237: 803-818
(70) Radiographics 2006; Chong S, et al. Neuroendocrine tumors of the lung: clinical, pathologic, and imaging findings. 26: 41-58
(71) J Nucl Med 2006; Hashimoto Y, et al. Accuracy of PET for diagnosis of solid pulmonary lesions with 18F-FDG uptake below the standardized uptake value of 2.5. 47: 426-431
(72) J Nucl Med 2006; Yi CA, et al. Tissue characterization of solitary pulmonary nodule: comparative study between helical dynamic CT and integrated PET/CT. 47: 443-450
(73) J Nucl Med 2006; Bunyaviroch T, Coleman RE. PET evaluation of lung cancer. 47: 451-469
(74) AJR 2006; Shim SS, et al. Focal parenchymal lung lesions showing a potential false-positive and false-negative interpretations on integrated PET/CT. 186: 639-648
(75) J Nucl Med 2006; Prevost S, et al. Bone marrow hypermetabolism on 18F-FDG PET as a survival prognostic factor in non-small cell lung cancer. 47: 559-565
(76) J Nucl Med 2006; Shankar LK, et al. Consensus recommendations for the use of 18F-FDG PET as an indicator of therapeutic response in patients in national cancer institute trials. 47: 1059-1066
(77) AJR 2006; Chrietensen JA, et al. Characterization of the solitary pulmonary nodule: 18F-FDG PET versus nodule-enhancement CT. 187: 1361-1367
(78) J Nucl Med 2006; Biehl KJ, et al. 18F-FDG PET definition of gross tumor volume for radiotherapy of non-small cell lung cancer: is a single standardized uptake value threshold approach appropriate? 47: 1808-1812
(79) J Nucl Med 2007; Kim SK, et al. Accuracy of PET/CT in characterization of solitary pulmonary lesions. 48: 214-220
(80) Chest 2007; Daniels CE, et al. The utility of fluorodeoxyglucose positron emission tomography in the evaluation of carcinoid tumors presenting as pulmonary nodules. 131: 255-260
(81)
(82) J Nucl Med 2007; Meirelles GSP, et al. Deep-inspiration breath-hold PET/CT: clinical findings with a new technique for detection and characterization of thoracic lesions. 48: 712-719
(83) J Nucl Med 2007; Nahmias C, et al. Time course of early response to chemotherapy in non-small cell lung cancer patients with 18F-FDG PET/CT. 48: 744-751
(84) AJR 2007; Chong S, et al. Integrated PET/CT of pulmonary neuroendocrine tumors: diagnostic and prognostic implications. 188: 1223-1231
(85) J Nucl Med 2007; de Geus-Oei LF, et al. Chemotherapy response evaluation with 18F-FDG PET in patients with non-small cell lung cancer. 48: 1592-1598
(86) Radiology 2008; Cronin P, et al. Solitary pulmonary nodules: meta-analytic comparison of cross-sectional imaging modalities for diagnosis of malignancy. 246: 772-782
(87) J Nucl Med 2008; Benz MR, et al. Treatment monitoring by 18F-FDG PET/CT in patients with sarcomas: interobserver variability of quantitative parameters in treatment-induced changes in histopathologically responding and non-responding tumors. 49: 1038-1046
(88) AJR 2008; Chen CJ, et al. Dual-phase 18F-FDG PET in the diagnosis of pulmonary nodules with an initial standard uptake value less than 2.5. 191: 475-479
(89) J Nucl Med 2008; Kawano T, et al. Deep-inspiration breath-hold PET/CT of lung cancer: maximum standarized uptake value analysis of 108 patients. 49: 1223-1231
(90) J Nucl Med 2008; Goudarzi B, et al. Diagnosis and differentiation of bronchoalveolar carcinoma from adenocarinoma with bronchoalveolar components with metabolic and anatomic characteristics using PET/CT. 49: 1585-1592
(91) J Nucl Med 2008; Nahmias C, Wahl LM. Reproducibility of standardized uptake value measurements determined by 18F-FDG PET in malignant tumors. 49: 1804-1808
(92) J Nucl Med 2009; Ben-Haim S, Ell P. 18F-FDG PET and PET/CT in the evaluation of cancer treatment response. 50: 88-99
(93) J Nucl Med 2009; Zhao B, et al. Imaging surrogates of tumor response to therapy: anatomic and functional biomarkers. 50: 239-249
(94) J Nucl Med 2009; Torizuka T, et al. Single 20-second acquisition of deep-inspiration breath-hold PET/CT: clinical feasibility for lung cancer. 50: 1579-1584
(95) AJR 2009; Werner MK, et al. Respiratory gating enhances imaging of pulmonary nodules and measurement of tracer uptake in FDG PET/CT. 193: 1640-1645
(96) J Nucl Med 2010; Chang G, et al. Implementation of an automated respiratory amplitude gating technique for PET/CT: clinical evaluation. 51: 16-24
(97) J Nucl Med 2010; Visser EP, et al. SUV: silly useless value to smart uptake value. 51: 173-175
(98) AJR 2010; Pommier P, et al. Impact of 18F-FDG PET on treatment strategy and 3D radiotherapy planning in non-small cell lung cancer: a prospective multicenter study. 195: 350-355
(99) J Nucl Med 2010; Singnurkar A, et al 18F-FDG PET/CT for the prediction and detection of local recurrence after radiofrequency ablation of malignant lung lesions. 51: 1833-1840
(100) AJR 2004; Jin GY, et al. Primary and secondary lung malignancies treated with percutaneous radiofrequency ablation: evaluation with followup helical CT. 183: 1013-1020
(101) Radiology 2010; Beland MD, et al. Primary non-small cell lung cancer: review of frequency, location, and time of recurrence after radiofrequency ablation. 254: 301-307
(102) Radiology 2011; Deandreis D, et al. Role of FDG PET/CT and chest CT in the follow-up of lung lesions treated with radiofrequency ablation. 258: 270-276
(103) Radiographics 2011; Purandare NC, et al. Therapeutic
response to radiofrequency ablation of neoplastic lesions: FDG
PET/CT findings. 31: 201-213
(104) AJR 2011; Yoo DC, et al. Radiofrequency ablation of
medically inoperable stage IA non-small cell lung cancer: are
early posttreatment PET findings predictive of treatment outcome?
197: 334-340
(105) Radiology 2011; Xie L, et al. Non-small cell lung cancer:
prognostic importance of positive FDG PET findings in the
mediastinum for patients with N0-N1 disease at pathologic
analysis. 261: 226-234
(106) J Nucl Med 2011; Benz MR, et al.
18F- FDG PET/CT for monitoring
treatment responses to the epidermal growth factor inhibitor
erlotinib. 52: 1684-1689
(107) J Nucl Med 2011; Kahraman D, et al.
Quantitative analysis of response to treatment with Erlotinib in
advanced non-small cell lung cancer using 18F-FDG
PET
and 3'-deoxy-3'- 18F-fluorothymidine PET. 52:
1871-1877
(108) AJR 2012; Kim TJ, et al. Is there a
role for FDG PET in the management of lung cancer manifesting
predominatly as ground-glass opacity? 198: 83-88
(109) J Nucl Med 2012; Lopez Gueera JL, et
al. Large decreases in standardized uptake values after
definitive radiation are associated with better survival of
patients with locally advanced non-small cell lung cancer. 53:
225-233
(110) J Nucl Med 2012; Bengtsson T, et al. 18F- FDG PET as a surrogate biomarker
in non-small cell lung cancer treated with erlotinib: newly
identified lesions are more informative than standardized uptake
value. 53: 530-537
(111) J Nucl Med 2012; Gregory DL, et al.
Effect of PET/CT on management of patients with non-small cell
lung cancer: results of a prospective study with 5-year survival
data. 53: 1007-1015
(112) Radiographics 2012; Abtin F,
et al. Radiofrequency ablation of lung tumors: imaging features of
the post-ablation zone. 32: 947-96
(113) Radiology 2012; Mandeville HC, et al. Operable non-small
cell lung cancer: correlation of volumetric helical dynamic
contrast-enhanced CT parameters with immunohistochemical markers
of tumor hypoxia. 264: 581-589
(114) J Nucl Med 2012; van Elmpt W, et al. Response assessment
using 18F-FDG PET early in the couse of radiotherapy
correlates with survival in advanced-stage non-small cell lung
cancer. 53: 1514-1520
(115) J Nucl Med 2013; Cook GJR, et al. Are pretreatment 18F-FDG
PET
tumor
textural features in non-small cell lung cancer associated with
response and survival after chemotherapy. 54: 19-26
(116) AJR 2013; Davison J, et al. PET-based primary tumor
volumetric parameters and survival of patients with non-small cell
lung carcinoma. 200: 635-640
(117) J Nucl Med 2013; Usmanij E, et al. 18F-FDG PET
early response evaluation of locally advanced non-small cell lung
cancer treated with concomitant chemoradiotherapy. 54: 1528-1534
(118) Radiology 2014; Satoh Y, et al. Volume-based parameters
measured by using FDG PET/CT in patients with stage I NSCLC
treated with sterotatic body radiation therapy: prognostic value.
270: 275-281
(119) J Nucl Med 2014; Antoniou A, et al. Follow-up or
surveillance 18F FDG PET/CT and
survival outcome in lung cancer patients. 55: 1062-1068
(120) Radiology 2014; Fluorine 18
fluorodeoxyglucose PET/CT volume-based indices in locally
advanced non-small cell lung cancer: prediction of residual
viable tumor after induction chemotherapy. 272: 875-884
(121) J Nucl Med 2014; Huang W, et al. Value
of metabolic tumor volume on repeated 18F FDG PET/CTfor early
prediction of survival in locally advanced non-small cell lung
cancer treated with concurrent chemoradiotherapy. 55: 1584-1590
(122) Radiographics 2014; Truong MT, et al. Update in the
evaluation of the solitary pulmonary nodule. 34: 1658-1679
(123) J Nucl Med 2015; Park SY, et al. Prognostic value of total
lesion glycolysis by 18F FDG
PET/CT in surgically resected stage IA non-small cell lung
cancer. 56: 45-49
(124) J Nucl Med 2015; Calais J, et al. Areas
of high 18F FDG uptake on
preradiotherapy PET/CT identify preferential sites of local
relapse after chemoradiotherapy for non-small cell lung cancer.
56: 196-203
(125) J Nucl Med 2015; Marcus C, et al.
18F FDG PET/CT and lung
cancer: value of fourth and subsequent posttherapy followup
scans for patient management. 56: 204-208
(126) J Nucl Med 2015; Weber WA, et al.
Repeatability of 18F FDG
PET/CT in advanced non-small cell lung cancer: prospective
assessment in 2 multicenter trials. 56: 1137-1143
(127) Radiology 2015; Cook GJR, et al.
Non-small cell lung cancer treated with Erlotinib: heterogeneity
of 18F FDG uptake at PET-
association with treatment response and prognosis. 276: 883-893
(128) AJR 2015; Hyun SH, et al. VOlume-based
assessment with 18F FDG
PET/CT improves outcome prediction for patients with stage
IIIA-N2 non-small cell lung cancer. 205: 623-628
(129) J Nucl Med 2016; Sheikhbahaei S, et al.
18F FDG PET/CT: therapy
response assessment interpretation (Hopkins criteria) and
survival outcomes in lung cancer patients. 57: 855-860
(130) Radiology 2016; Buther F, et al. Impact
of data-driven respiratory gating in clinical PET. 281: 229-238
(131) Radiology 2016; Kesner AL, et al.
Validation of software gating: a practical technology for
respiratory motion correction in PET. 281: 239-248
(132) AJR 2017; Sheikhbahaei S, et al. The
value of FDG PET/CT in treatment response assessment, followup,
and surveillance of lung cancer. 208: 420-433
(133) J Nucl Med 2017; Vera P, et al. Phase
II study of a radiotherapy total dose increase in hypoxic
lesions identified by 18F-misonidazole
PET/CT in patients with non-small cell lung carcinoma (RTEP5
study). 58: 1045-1053
(134) J Nucl Med
2017; Steiger S, et al. Analysis of prognostic values of various
PET metrics in preoperative 18F-FDG PET for
early-stage bronchial carcinoma for progression-free and overall
survival: significantly increased glycolysis is a predictive
factor. 58: 1925-1930
(135) Radiology 2018; Balamoutoff N, et al. Added value of a
single fast 20-second deep-inspiration breath-hold acquisition in
FDG PET/CT in the assessment of lung nodules. 286: 260-270
(136) J Nucl Med 2019; Guy-Anne T, et al. What 18F-FDG
PET response-assessment method best predicts survival after
curative-intent chemoradiation in non-small cell lung cancer:
EORTC, PERCIST, Peter Mac criteria, or Deauville criteria? 60:
328-334
(137) AJR 2019; Okazaki E, et al. Prognostic value of the
volumetric parameters of dual-time-point 18F-FDG
PET/CT in non-small cell lung cancer treated with definitive
radiation therapy. 213: 1366-1373
(138) AJR 2020; Shao X, et al. ROle of PET/CT in management of
early adenocarcinoma. 214: 437-445
(139) AJR 2020; Banks KP, et al. It's about quality, not quantity: qualitative FDG PET/CT criteria for therapy response assessment in clinical practice. 215: 313-324